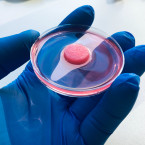

USA

S rozlohou 9,8 milionu kilometrů čtverečních jsou Spojené státy třetí největší zemí na světě (po Rusku a Kanadě). S téměř 340 miliony obyvatel jsou třetí nejlidnatější zemí planety (po Číně a Indii). Populace je tradičně koncentrována na obou pobřežích, na východním leží největší město Spojených států New York, na západním pobřeží druhé největší město Los Angeles. Hlavním městem je Washington. Co všchno o zemi neomezených možností ještě stále nevíme?
Stránky
- « první
- ‹ předchozí
- …
- 7
- 8
- 9
- 10
- 11
- 12
- 13
- 14
- 15
- následující ›
- poslední »